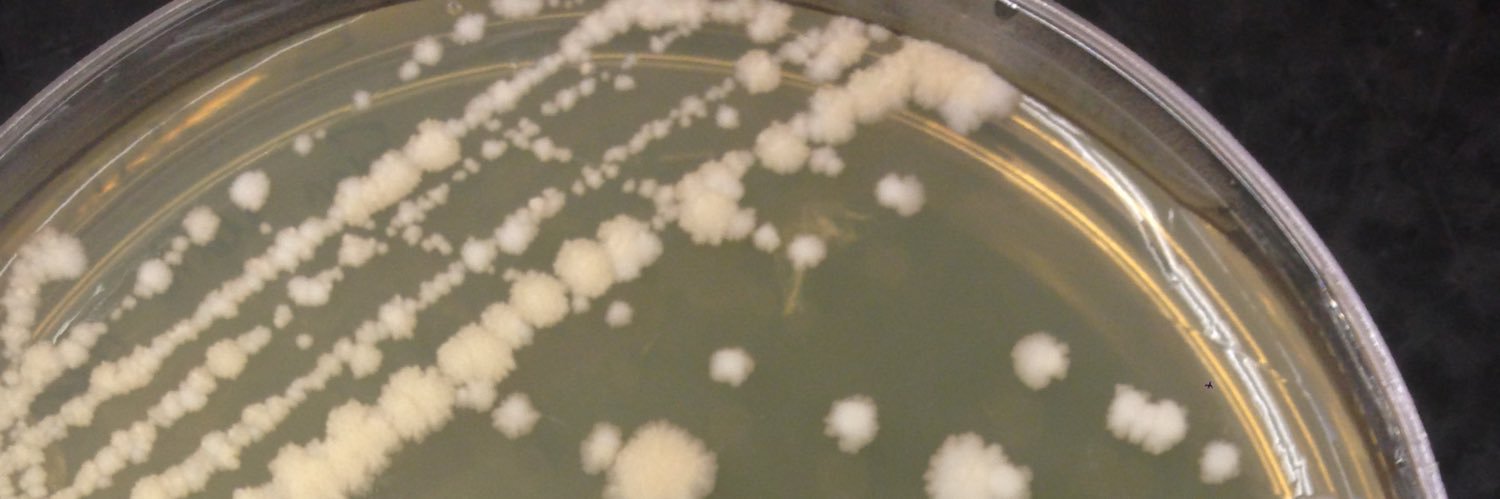
Bea Baselga Cervera,PhD,DVM 🇪🇸🇺🇸 banner

Bea Baselga Cervera,PhD,DVM 🇪🇸🇺🇸 retweetledi

Applications for a talk at the GRS on Quantitative Genetics and Genomics are due November 10, 2024 (in 2 days!!). We are still looking for more graduate students and postdocs to attend. Applications for poster-only attendance are due January 18th. grc.org/quantitative-g…
English